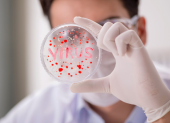
Nueve macacos adultos fueron infectados con el virus SARS-CoV-2.

En Picaihua, parroquia de Ambato, le sacan provecho al aguacate, la ‘pera de los incas’
Jorge Alvarado
Un grupo de emprendedores elabora queso de aguacate para vender en ferias. La cáscara y hasta la pepa sirven para varias preparaciones

Jorge Alvarado
Un grupo de emprendedores elabora queso de aguacate para vender en ferias. La cáscara y hasta la pepa sirven para varias preparaciones

Modesto García
El presidente de Barcelona considera que de esta manera se llevará más alegría a los hinchas, en medio de la crisis por la pandemia

Mariella Toranzos
El ministerio de Agricultura y Ganadería es el encargado de emitir el reglamento para la siembra de este producto, parte de la familia del cannabis.

Guillermo Lizarzaburu
El precio del crudo WTI de Texas (Estados Unidos) aumentó este 21 de mayo 1,28 %. Las finanzas de Ecuador se recuperan.
Giannella Espinoza
Nueve macacos adultos vacunados con el virus SARS-CoV-2 y recuperados, fueron expuestos a una segunda infección 35 días después y todos ellos mostraron "ningún síntoma"

Herbert Holguín
Se necesitaría un milagro económico para que los resultados favorezcan a Donald Trump, según estudio de Oxford Economics

Javier Montenegro
El 18 de mayo existía disponible una sola cama de cuidados intensivos en toda la provincia de Pichincha

Rhonny Rodríguez
Según la Asociación de Municipalidades del Ecuador (AME) la deuda bordea los 600 millones de dólares. Deberá justificar el atraso

Alejandro Puga
La banda española se junta nuevamente con Belinda para llevar la frescura del verano a cada una de las casas de sus seguidores

Santiago San Miguel
Desde Miami, el actor venezolano, habló de la novela que lo lanzó a la fama, su trabajo más reciente en Televisa y lo que pospuso por la pandemia.





Más visto